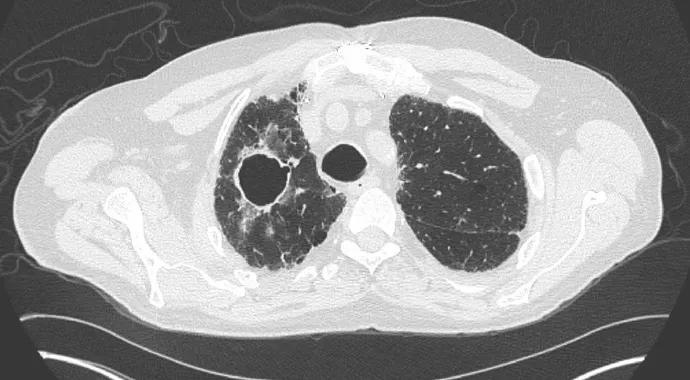

New cavity should prompt assessment of other organ sites
Image content: This image is available to view online.
View image online (https://assets.clevelandclinic.org/transform/fdf57e95-0acc-4c7c-ae5d-a8d2d1f523f4/Langford-690x380_jpg)
Langford-690×380
Advertisement
Cleveland Clinic is a non-profit academic medical center. Advertising on our site helps support our mission. We do not endorse non-Cleveland Clinic products or services. Policy
Cavitating lung nodules are defined radiographically as a lucency within the lung tissue that may or may not contain a fluid level and that is surrounded by a wall of varied thickness. Pulmonary cavities occur commonly in granulomatosis with polyangiitis (GPA) (Wegener’s). However, while a lung cavity may develop as a result of active disease in a patient with GPA, other causes must also be considered, as exemplified by the following cases from our institution.
A 55-year-old man with GPA on maintenance mycophenolate mofetil presented with palpable purpura and sinonasal symptoms that included increased epistaxis and nasal crusting. Despite a lack of chest symptoms, computed tomography (CT) was performed and revealed cavitary lung disease (Figure 1). Following a bronchoscopy that was negative for infection, induction therapy with prednisone and methotrexate was started, and the patient had complete resolution of the cavity on follow-up imaging.

Image content: This image is available to view online.
View image online (https://assets.clevelandclinic.org/transform/0762d0d0-6cf5-4783-aafb-c81a6fb36f5d/Langford-fig1_jpg)
Figure 1.
A 22-year-old man with GPA on maintenance methotrexate developed streaky hemoptysis and was found to have worsening cavitary lung lesions. After a bronchoscopy was negative for infection, induction therapy with prednisone and cyclophosphamide was started. After initial improvement, the patient was transitioned to azathioprine, after which the pulmonary cavities grew (Figure 2). Bronchoscopy now revealed Aspergillus fumigatus. After treatment with antifungal therapy, the cavitary lesions improved. The patient subsequently developed a relapse of GPA and has done well on rituximab combined with voriconazole.
Advertisement

Image content: This image is available to view online.
View image online (https://assets.clevelandclinic.org/transform/c129721b-d1cb-491d-8fc3-1a21337e0719/Langford-fig2_jpg)
Figure 2.
A 66-year-old man had a history of GPA that originally presented with sinus disease, alveolar hemorrhage, pauciimmune crescentic glomerulonephritis and a positive myeloperoxidase antineutrophil cytoplasmic antibody (ANCA). While on maintenance azathioprine, he developed a harsh productive cough with a new cavitary lung lesion without evidence of active disease involving other organs (Figure 3). A sputum culture grew Mycobacterium avium complex (MAC), and the patient was started on antimicrobials. Despite this treatment, the lesion worsened. Bronchoscopy was negative for MAC or other infection with an unremarkable cytologic examination. A thoracoscopic biopsy revealed a poorly differentiated non-small-cell lung carcinoma.

Image content: This image is available to view online.
View image online (https://assets.clevelandclinic.org/transform/df7dd77a-61ab-4c0f-9a78-354939e626f5/Langford-fig3_jpg)
Figure 3.
A 36-year-old woman was diagnosed with GPA after presenting with massive pulmonary cavities and subglottic stenosis (Figure 4). Confirmatory histology was obtained from subglottic and transbronchial biopsies, and she had positive proteinase 3 ANCA. She was treated with prednisone and cyclophosphamide with initial improvement. After eight weeks, she developed increased cough and fever. While some cavities had improved, others had enlarged and developed satellite lesions (Figure 5). Bronchoscopy was performed twice and did not reveal infection. Surgical biopsy was considered but carried a high risk due to the size of the cavities. After discussion with pulmonary and infectious disease consultants, the patient received broad empiric treatment for bacterial and fungal organisms. After four weeks of antimicrobial therapy during which her lesions stabilized but did not improve, she was treated with rituximab. Her CT findings gradually improved (Figure 6 shows the same area of lung parenchyma as in Figure 5), allowing reduction in prednisone and discontinuation of the antimicrobials.
Advertisement

Image content: This image is available to view online.
View image online (https://assets.clevelandclinic.org/transform/1136afba-5063-4d93-b141-09022cc78357/Langford-fig4_jpg)
Figure 4.

Image content: This image is available to view online.
View image online (https://assets.clevelandclinic.org/transform/898a855d-7623-4603-ab39-710c27b84ea2/Langford-fig5_jpg)
Figure 5.

Image content: This image is available to view online.
View image online (https://assets.clevelandclinic.org/transform/040315eb-2bb9-4e33-8c2c-82babf0a29da/Langford-fig6_jpg)
Figure 6.
Cavitary lung lesions carry a broad differential diagnosis that includes the following in addition to vasculitis: neoplasm, embolism with infarction, pulmonary sequestration, bullae/cysts with fluid, bronchiectasis and a wide spectrum of infections ranging from aerobic and anaerobic bacteria to mycobacteria and fungi. Even in patients who have a firmly established diagnosis of GPA, cavities may not always be the result of active disease. It is also possible, particularly in an immunosuppressed patient with GPA, for two causes to be present in which a cavity formed by active disease becomes superinfected.
As seen in the cases profiled here, cavitary lung disease in GPA can present with cough, hemoptysis, dyspnea, pleuritic chest pain or even no symptoms, as in Case 1. The development of a new cavity should prompt a careful assessment for active disease in other organ sites. Even when this is found, however, evaluation should be performed to rule out infection prior to aggressive immunosuppression. If no infection is found and the patient is treated for GPA, cavities must be monitored radiographically to confirm that they respond to therapy. A cavity that worsens with immunosuppression should heighten concern for a superimposed process. In some instances, bronchoscopy may reveal an organism, as in Case 2, or a surgical biopsy may be required, as in Case 3.
There are currently no factors short of microbiologic and histologic analysis that can determine whether a cavity in a patient with GPA may be due to another cause. Characteristics of the cavity such as wall thickness, intracavitary fluid/material, fever, acute-phase reactants or ANCA are not helpful in this regard.
Advertisement
Pulmonary cavities in patients with GPA can be very treatment-responsive, as in Case 1. When their course is complex, detection and treatment of the contributing factors can bring about a reduction in cavitary size and clinical improvement.
These cases highlight how multidisciplinary collaboration at Cleveland Clinic ‒ among rheumatologists, pulmonologists, radiologists, thoracic surgeons and infectious disease experts ‒ yields benefits for the assessment and management of GPA patients who have complex cavitary pulmonary disease.
Dr. Langford is Director of the Center for Vasculitis Care and Research as well as Vice Chair for Research for the Department of Rheumatic and Immunologic Diseases.
Advertisement
Advertisement
Treatment strategies require understanding of pathomechanisms
Education, prevention strategies and monitoring serves this at-risk group
Treatment for scleroderma can sometimes cause esophageal symptoms
Lupus Clinic providers collaborate to advance treatment and understanding
Older Psoriasis Patients May Experience Quicker Transition
Cleveland Clinic’s Rheumatic Lung Disease program treats patients with complex conditions
Symptoms complement one another
E-coaching program is tailored for those with the disease